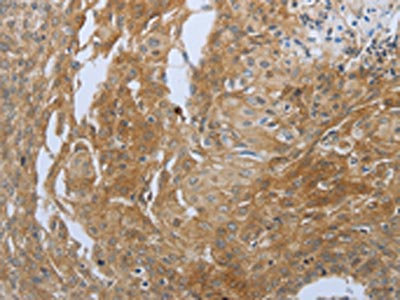

SHBG Antibody
-
中文名稱:SHBG兔多克隆抗體
-
貨號:CSB-PA787439
-
規格:¥1100
-
圖片:
-
The image on the left is immunohistochemistry of paraffin-embedded Human cervical cancer tissue using CSB-PA787439(SHBG Antibody) at dilution 1/20, on the right is treated with synthetic peptide. (Original magnification: ×200)
-
The image on the left is immunohistochemistry of paraffin-embedded Human ovarian cancer tissue using CSB-PA787439(SHBG Antibody) at dilution 1/20, on the right is treated with synthetic peptide. (Original magnification: ×200)
-
-
其他:
產品詳情
-
Uniprot No.:
-
基因名:SHBG
-
別名:ABP antibody; Androgen binding protein antibody; SBP antibody; Sex hormone-binding globulin antibody; Sex steroid binding protein antibody; Sex steroid-binding protein antibody; SHBG antibody; SHBG_HUMAN antibody; TeBG antibody; Testis specific androgen binding protein antibody; Testis-specific androgen-binding protein antibody; Testosterone binding beta globulin antibody; Testosterone estradiol binding globulin antibody; Testosterone estrogen binding globulin antibody; Testosterone-estradiol-binding globulin antibody; Testosterone-estrogen-binding globulin antibody
-
宿主:Rabbit
-
反應種屬:Human,Mouse,Rat
-
免疫原:Synthetic peptide of Human SHBG
-
免疫原種屬:Homo sapiens (Human)
-
標記方式:Non-conjugated
-
抗體亞型:IgG
-
純化方式:Antigen affinity purification
-
濃度:It differs from different batches. Please contact us to confirm it.
-
保存緩沖液:-20°C, pH7.4 PBS, 0.05% NaN3, 40% Glycerol
-
產品提供形式:Liquid
-
應用范圍:ELISA,IHC
-
推薦稀釋比:
Application Recommended Dilution ELISA 1:1000-1:5000 IHC 1:25-1:100 -
Protocols:
-
儲存條件:Upon receipt, store at -20°C or -80°C. Avoid repeated freeze.
-
貨期:Basically, we can dispatch the products out in 1-3 working days after receiving your orders. Delivery time maybe differs from different purchasing way or location, please kindly consult your local distributors for specific delivery time.
-
用途:For Research Use Only. Not for use in diagnostic or therapeutic procedures.
相關產品
靶點詳情
-
功能:Functions as an androgen transport protein, but may also be involved in receptor mediated processes. Each dimer binds one molecule of steroid. Specific for 5-alpha-dihydrotestosterone, testosterone, and 17-beta-estradiol. Regulates the plasma metabolic clearance rate of steroid hormones by controlling their plasma concentration.
-
基因功能參考文獻:
- SHBG suppresses inflammation and lipid accumulation in macrophages and adipocytes, which might be among the mechanisms underlying the protective effect of SHBG, that is, its actions which reduce the incidence of metabolic syndrome PMID: 30046278
- SHBG served as a major predictor for the risk of MetS and was correlated with serum adiponectin and leptin levels that are independent of T. PMID: 28577342
- Low SHBG expression not only participates in the development of local insulin resistance, but may also play an important role in PI3K/AKT pathway-mediated systemic insulin resistance and gestational diabetes. PMID: 29298529
- Fibulin-1 is expressed in breast cancer cell lines, interacts wtih SHBG, and is increased by estradiol PMID: 29940241
- These data, therefore, reflected that SHBG single nucleotide polymorphism rs6259 causes changes in placental SHBG concentration and may play a functional role in the molecular mechanisms of the gestational diabetes mellitus etiology. PMID: 29484425
- This is the first study that provides detailed analyses of SHBG with metabolic syndrome components in male diabetic subjects. PMID: 29245159
- in postmenopausal women, aromatase activity could be an important determinant of skeletal health. PMID: 29329467
- Consumption of high coffee and caffeine is associated with a reduced risk of low SHBG, an established risk marker for T2DM, which might contribute to the protective effects of coffee for type 2 diabetes. PMID: 28664630
- Circulating sex steroids, prolactin, insulin-like growth factor (IGF) I, IGF-binding protein 3, and sex hormone-binding globulin (SHBG) were evaluated using backward elimination separately in women pre- and postmenopausal at blood collection. PMID: 28246273
- Patient-associated features such as body mass index and serum levels of Testosterone and SHBG can improve the predictive capability of consolidate tumor-specific biomarkers in both pre- and postmenopause. PMID: 29474646
- relationship of testosterone, sex hormone-binding globulin (SHBG), and IGF-1 with bone mineral density (BMD) and bone turnover markers (BTMs) in Korean men, is reported. PMID: 27873076
- SHBG increased total androgen and estrogen concentrations via hypothalamic-pituitary feedback regulation and prolonged ligand half-life. PMID: 27748448
- low serum SHBG is associated with insulin resistance in men with nonalcoholic fatty liver disease. PMID: 28282659
- no association was seen between the stuttering and digit ratio, progesterone, or SHBG PMID: 28992603
- there is limited clinical utility of serum Estradiol, Testosterone, and SHBG measures for the evaluation of osteoporosis risk in elderly men. PMID: 27753150
- endogenous steroid hormone, sex hormone-binding globulin, and precursor steroids are associated with hemostatic factors in postmenopausal women PMID: 27797446
- cross-sectional associations between individual bioavailable sex hormones and SHBG with radiographically assessed kyphosis, were examined. PMID: 27355438
- Temporal change in serum SHBG, but not Testosterone, Estradiol, or other hormonal variables, was significantly associated with any, nonvertebral or hip fracture incidence in univariable analyses. PMID: 27363725
- In vitro androgen bioactivity reflects the inhibitory effects of SHBG. PMID: 27576188
- In men with hepatic steatosis, we found that elevated serum ALT levels were associated with lower serum SHBG levels. PMID: 28540984
- In the total population adjusting for race/ethnicity, there was no association between SHBG and fracture in women. The interaction between race/ethnicity and SHBG was also not statistically significant. PMID: 28324031
- Depression and anxiety in subfertile males are associated with lower secretion of SHBG. PMID: 28456148
- UBQLN4, APP, CTNNB1, SHBG, and COL1A1 might be involved in the development of nonalcoholic fatty liver disease, and are proposed as the potential markers for predicting the development of this condition PMID: 28796060
- Male infertility is associated with GA genotype and A allele of rs6259 locus, as well as CC genotype of rs727428 locus in SHBG gene PMID: 28796064
- Low serum SHBG was the most relevant factor for prediabetes and diabetes PMID: 27583401
- two non-linked SNPs (rs6259 and rs9901675) at the SHBG gene locus might be of importance for language impairment problems in boys. PMID: 26930261
- Data suggest there is a strong inverse correlation between SHBG (sex hormone-binding globulin) and DHEA (dehydroepiandrosterone) levels in cord blood obtained at birth from infants of both sexes; there are no associations between SHBG and testosterone or DHT (dihydrotestosterone) levels. This study was conducted in Sweden. PMID: 28373106
- modulates hepatic lipogenesis; reduction of SHBG plasma levels in obese and type 2 diabetic subjects could be directly associated with nonalcoholic fatty liver disease development through an increase in hepatic lipogenesis PMID: 28359088
- Short-term weight reduction program (WRP) has the potential effects of lowering body weight, mass index, body fat percentage, and fat weight and increasing serum HDL-C levels and insulin sensitivity in obese children. Although serum SHBG levels moderately increased in both sexes during short-term WRP, change in SHBG concentrations might be a potential biomarker to evaluate improvement in insulin resistance in girls only. PMID: 28489766
- SHBG was inversely associated with the risk of type 2 diabetes in women. [Meta-Analysis] PMID: 28223343
- Osteocalcin and Sex Hormone Binding Globulin Compete on a Specific Binding Site of GPRC6A. PMID: 27673554
- Low sex hormone-binding globulin (SHBG) in conjunction with high estradiol has an additive detrimental effect on the risk of type 2 diabetes (T2D) in men. PMID: 26119029
- we genotyped five hormone-related genes: estrogen receptor-alpha (ESR1), aromatase (CYP19), catechol-O-methyl transferase (COMT), sex hormone-binding globulin (SHBG)and glutathione S-transferase (GSTP1). Our data demonstrate that these ESR1, GSTP1, and CYP19 polymorphisms are associated with risk of BC, and the risk haplotype TGGGGTC could help to identify populations with high susceptibility to BC in Chinese women. PMID: 27323034
- cortisol/testosterone and cortisol/sex hormone-binding globulin ratios are useful biomarkers for atherosclerosis in middle-age women PMID: 27031578
- Data show that low that low globulin (GLB) levels were significantly associated with favorable survival, and low ALB levels were associated with a significantly worse survival PMID: 26476541
- Sex hormone-binding globulin has no effect on salivary testosterone. PMID: 27117450
- In hormonal contraceptive users, SHBG was positively associated with both activated protein C (APC) resistance and baseline TG, and protein S and prothrombin were important mediators. These data provide further evidence that SHBG may be used as a biomarker in assessing prothrombotic profile of hormonal contraception. PMID: 27323874
- No significant differences were observed in serum ABP levels in all male farmers between the two groups with different fluoride exposure. These results supported that excess fluoride exposure decreased serum T levels of male farmers with age-specificity. PMID: 27154732
- results indicated that there was a significant association between migraine and gene-gene interaction among the CYP19A1, FSHR, ESR1 and NRIP1. PMID: 27019440
- Polymorphisms of SHBG or the neighboring genes were associated with SHBG levels or BMD and osteoporosis PMID: 26657339
- high SHBG predicts incident clinical and radiographic vertebral fractures in elderly men. PMID: 26391196
- After early childhood, serum sex hormone-binding globulin declines to a nadir in males at the age of 20 years and remains stable till the sixth decade with a gradual, progressive rise thereafter. In females, the sex hormone-binding globulin nadir is reached earlier with levels rising gradually and progressively with age thereafter and accelerating after the age of 70 years PMID: 26438522
- higher SHBG (but not testosterone or estradiol) is an independent risk factor for vertebral fractures in older men. PMID: 26778261
- We found that elevated levels of estradiol and SHBG in HT [Hormone therapy] users were associated with elevated levels of CRP and lower levels of TFPI, both of which may be related to a prothrombotic milieu in HT [Hormone therapy ]users. PMID: 26700933
- There was a drop in SHBG levels in the first week of smoking cessation and levels continued to remain low. PMID: 26680482
- SHBG was higher in both obese and non-obese PCOS patients compared to healthy controls. PMID: 26291814
- Specific SHBG variants affecting serum SHBG levels and SHBG haplotypes are associated with polycystic ovary syndrome, suggesting the role for SHBG as polycystic ovary syndrome candidate gene. PMID: 26600064
- overlapping of interacting amino acid residues between phthalate compounds and natural ligand, dihydrotestosterone, suggested potential disrupting activity of phthalates in the endocrine homeostasis function of SHBG PMID: 26963243
- Data suggest that, in endurance runners using endurance training followed by strength training, an initial reduction in testosterone/SHBG ratio is seen after 12 weeks followed by large increase in weeks 12-24 (as compared to endurance training alone). PMID: 25494869
- SHBG levels were lower in women with polycystic ovary syndrome compared to controls. PMID: 25020276
顯示更多
收起更多
-
亞細胞定位:Secreted.
-
組織特異性:Isoform 1 and isoform 2 are present in liver and testis.
-
數據庫鏈接:
Most popular with customers
-
-
YWHAB Recombinant Monoclonal Antibody
Applications: ELISA, WB, IHC, IF, FC
Species Reactivity: Human, Mouse, Rat
-
Phospho-YAP1 (S127) Recombinant Monoclonal Antibody
Applications: ELISA, WB, IHC
Species Reactivity: Human
-
-
-
-
-